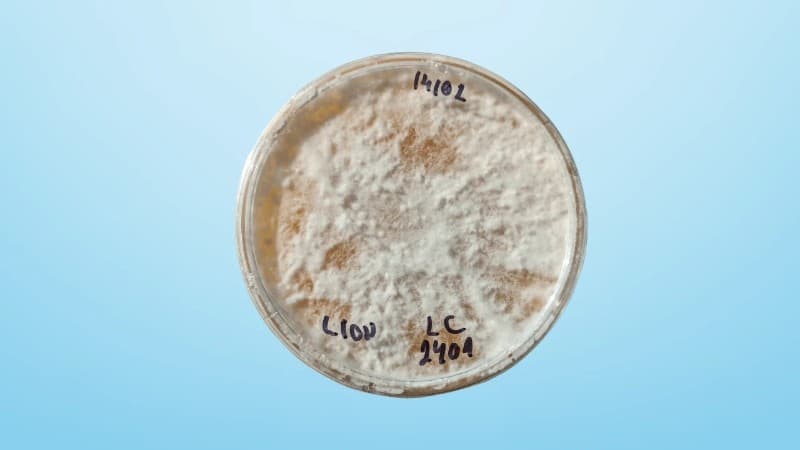
Lion’s Mane Agar Plate Clone

Click to zoom
Lion’s Mane Agar Plate Clone
£6.99
100% Positive
Only 3 left
Fast Delivery
🔬 Product Overview
Step into the world of high-grade mushroom cultivation with our Lion’s Mane Agar Plate Clone Culture. Professionally prepared and contamination-free, this plate contains genetically superior mycelium ideal for propagation into grain spawn, liquid culture, or direct inoculation. Whether you're a hobbyist or a commercial grower, this culture offers a strong foundation for lush, healthy growth.
✨ Features & Benefits
- 🧬 Clean & Strong Genetics Carefully selected clone culture ensures vigorous colonization and consistent fruiting.
- 🔄 Versatile Application Use to inoculate grain spawn, create liquid cultures, or transfer to new agar plates.
- 🛡️ Contamination-Free Guarantee Each plate is prepared under sterile conditions and inspected for purity.
- 🌱 For All Skill Levels Perfect for beginners exploring mycology or experienced growers scaling up production.
🎯 Perfect For
- Hobbyists looking to explore mushroom cultivation with a clean starting point
- Professional growers seeking high-yield, genetically stable cultures
- DIY kit builders expanding their own spawn and substrate systems
⚠️ Important Reminder
Always use aseptic technique when transferring or expanding agar cultures. Contamination can occur if proper sanitation is not maintained. We are not responsible for contamination after delivery — please handle with care.
100% Natural
Premium Quality
Fast Growing
Beginner Friendly
Free Shipping
Over £50
Returns
30 days free
Payment
100% secure
What's Included
Petri Dish with Lion’s Mane Clone Culture
Sealed Packaging – parafilm-wrapped and shipped in protective container
Support Access – expert guidance for successful propagation
Specifications
Species:Hericium erinaceus (Lion’s Mane)
Culture Type:Clone culture on nutrient agar
Sterility:Prepared under laminar flow hood
Shelf Life:4–6 weeks refrigerated; best used fresh
Application:Grain spawn, liquid culture, agar expansion
User Level:Beginner to advanced cultivators